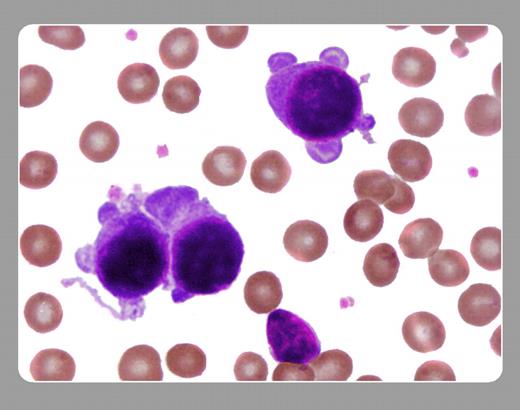

Topics:
acute megakaryocytic leukemias
Usually the marrow in acute megakaryoblastic leukemia is not aspirable, but it was in this case, with three megakaryoblasts showing granular basophilic cytoplasm and cytoplasmic pseudopod formation.
THE ASH IMAGE BANK, a reference and teaching tool, is continually updated with new atlas images and images of case studies. For more information or to contribute to the Image Bank, visit www.ashimagebank.org.
Copyright © 2003 The American Society of Hematology
2003